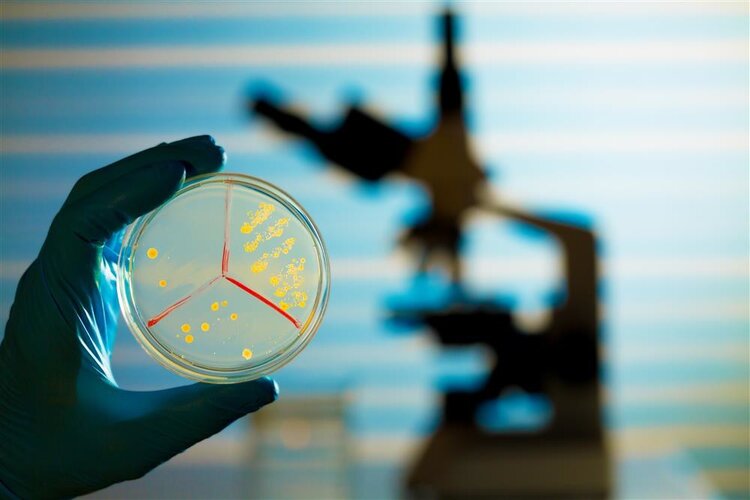

39健康网|易被误诊,死亡率高!美国出现罕见传染病,可用于制造生化武器

文章图片
文章图片

不是新冠病毒 , 不是德尔塔毒株 , 也不是拉姆达毒株!
《纽约每日新闻》当地9日报道 , 据美国疾控中心统计 , 得克萨斯州、佐治亚州、明尼苏达州和堪萨斯州发现4例罕见类鼻疽确诊病例 , 其中2名患者已死亡 。 最近一例是佐治亚州一名身份不明的男子 , 染病7个月后不治身亡 。
?图源网络
类鼻疽是一种地方性疾病 , 常见于热带和亚热带地区 , 极易被误诊 , 死亡率极高 , 一般通过旅行感染 。 但是 , 美国这次曝光的4名患者均无出国记录 。 美国CDC表示 , 他们有可能是通过接触进口产品感染 , 例如进口食品、药品、个人护理或清洁产品等 。
一、类鼻疽又称“泥土病” , 死亡率高
类鼻疽 , 俗称“泥土病” , 由类鼻疽伯克霍尔德菌感染引起 。
类鼻疽伯克霍尔德菌简称“类鼻疽菌” , 是一种土壤腐生菌 , 广泛存在于土壤和泥水中 , 尤其是热带、亚热带地区的水稻田和烂泥等潮湿土壤 , 会感染猪、马、羊等动物以及人类 。
全球的类鼻疽病例主要集中在越南、马来西亚、缅甸和澳大利亚北部 , 可通过皮肤伤口接触土壤和水源感染 , 也可经由吸入微尘、饮用水源而感染 , 可能透过接触患者的体液进行“人传人” 。
?类鼻疽潜伏期通常为2-4周 , 但也可短至2天 , 或长达数月、数年 , 第9天为发病高峰期 , 可导致脓肿和血液中毒 , 患者出现局部感染、肺炎、脑膜炎、败血症或慢性化脓性感染 , 伴有发烧、头痛、局部肿胀或痛楚、溃疡、咳嗽、胸痛、咳血和局部淋巴肿大等症状 。
由于初期症状不明显 , 仅为咳嗽、发烧、乏力、肌肉酸痛等 , 因此常被误以为是感冒 , 从而错过治疗时机 。 一旦病菌侵袭肺部 , 造成肺部发炎性浸润及严重败血症 , 死亡率可高达90% 。
二、发病率上升 , 被列为生化武器
类鼻疽主要在热带地区流行 , 我国海南、广东、广西、香港和台湾等南部地区也是发病流行区 。 近年来 , 全球类鼻疽病例在逐渐增加 , 随着旅游业的快速发展 , 它的影响也在逐渐扩大 。
类鼻疽菌有传染性强、致死率高、耐药性强的特点 , 目前没有疫苗 , WHO已将其列为B类生物恐怖源 , 美国CDC将其列为Ⅰ类生物恐怖源 , 被认为是一种潜在的生化武器 。
?资料显示 , 免疫力较差的人、老年人、慢性疾病患者、农民、军人、矿工以及长期接触大自然水源和泥土的户外工作者 , 是类鼻疽的高危易感人群 。
三、如何预防类鼻疽?
类鼻疽虽不常见 , 但其危害极大 , 国内外均有偶发病例 。 想要预防类鼻疽 , 需从以下几点着手 。
【39健康网|易被误诊,死亡率高!美国出现罕见传染病,可用于制造生化武器】1、雨天避免接触土壤
多项研究指出 , 类鼻疽病的流行与台风、雨水密切相关 。 我国海南省1997-2007年的类鼻疽病例中 , 90.9%的患者发病时间集中在多雨秋季 , 而澳大利亚则有85%的类鼻疽病例发生在季风季节 。
因此 , 如果你处于热带或亚热带地区 , 雨天尽量避免外出 , 以防接触受污染的土壤或泥水 。 如果要进行相关活动 , 应佩戴手套并穿上防水靴 , 并及时进行清洗或淋浴 。 另外 , 前往类鼻疽流行区的旅行者要注意饮食卫生 , 不要喝生水 。
经验总结扩展阅读
- |煤气灯效应:为什么智商高、家教好的女生更容易被渣男盯上?
- 婚姻 容易被已婚男人惦记的女人,往往都有三种通病,希望你没有
- 罐头 高智商的人真的更不容易被骗吗?|每日罐头
- 离异男 和男人越走越近时,女人最容易被蒙蔽的3点
- 的作用超市里的4款眼霜,容易被忽略,其实是“大佬”
- 恋爱|感情上容易被骗的女人,多半有这3个特征
- 因为玫瑰痤疮:一种极易被误诊的皮肤病!和痘痘怎么区分?
- 对当妈的人来说 20分钟被骗走12个娃!这类孩子最容易被拐,年关将近要盯紧
- 今天我们来说一说 男女交往中,最容易被女性看不起的四种男生,希望你不是其中之一
- 爱情 男女交往中,最容易被女性看不起的四种男生,希望你不是其中之一
